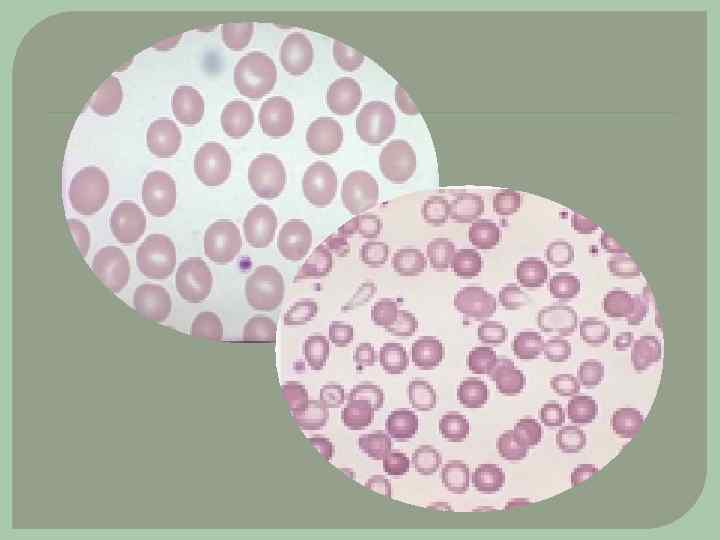

Анемии у детей .pptx
- Количество слайдов: 24

Заболевания крови у детей Лекция по дисциплине «СД в педиатрии»

Кроветворные органы это органы, служащие местом образования форменных элементов крови. красный костный мозг печень селезенка лимфатические узлы

Анемия патологическое состояние, характеризующееся снижением содержания Hb , часто в сочетании с уменьшением Эр в единице объема крови. КЛАССИФИКАЦИЯ АНЕМИЙ По степени тяжести анемии: легкая (Нв 90 120 г/л) средняя (Нв 70 90 г/л) тяжелая (Нв менее 70 г/л) По механизму развития: Анемии в результате кровопотери (постгеморрагические) Анемии в результате повышенного кроворазрушения (гемолитические) Анемии в результате недостаточного кровообразования (дефицитного эритропоэза)

Железодефицитная анемия патологическое состояние, развивающееся в результате дефицита железа в организме вследствие нарушения его поступления, усвоения или патологических потерь. По данным ВОЗ нижней границей нормы гемоглобина следует считать: 110 г/л у детей до 6 лет 120 г/л у детей старше 6 лет.

Этиология Антенатальные причины: q недоношенность q плацентарная недостаточность (тяжелые гестозы, угроза прерывания беременности, заболевания матери) q многоплодная беременность q анемия матери. Интранатальные причины: q кровотечения вследствие травматических акушерских пособий q аномалии развития плаценты или сосудов пуповины q поздняя или преждевременная перевязка пуповины Постнатальные причины: q недостаточное поступлении железа с пищей (нерациональное питание) q повышенные потребности в железе у детей с ускоренными темпами роста (недоношенные, новорожденных с большой массой тела при рождении, дети второго полугодия и второго года жизни, пре и пубертатный возраст) q избыточные потери железа (нарушениями процессов кишечного всасывания или кровотечения (инвазии кровососущих глистов, обильные и длительные маточные выделения у девочек в период становления менструального цикла в пубертате и др. ) )

Патогенез ЖДА Прелатентный дефицит характеризуется истощением запасов железа в паренхиматозных органах, мышцах, костном мозге. Уровень гемоглобина в пределах нормы. Клинических проявлений нет. Латентный дефицит железа характеризуется снижением содержания сывороточного железа. Гемоглобин в пределах нижней границы нормы. Появляется симптоматика. Анемия заключительная стадия дефицита железа. Развивается, когда исчерпаны его запасы в организме. Снижение железа в крови и в костном мозге нарушает процесс образования гемоглобина и ухудшаются процессы доставки к тканям кислорода. Нарушается деятельность практически всех органов и систем.

Клиническая картина Латентный дефицит железа проявляется сидеропеническим синдромом: изменения со стороны эпителия, астеновегетативные нарушения, снижение местного иммунитета. Эпителиальный синдром (трофические изменениями кожи, ногтей, волос и слизистых оболочек). - бледность кожи и слизистых. сухость кожи, в углах рта –трещины волосы жесткие, ломкие, сухие, выпадают ногти тонкие, ломаются, ложкообразной формы сглаживание сосочков языка извращение вкуса и обоняния частые риниты, стоматиты

Клиническая картина Астеновегетативные нарушения изменение эмоционального тонуса раздражительность, апатия, повышенная утомляемость, при длительном дефиците Fe отставание в психомоторном развитии. Синдром снижения иммунитета повышенная заболеваемость острыми респираторными и кишечными инфекциями. При развитии железодефицитной анемии присоединяются изменения со стороны сердечно сосудистой системы тахикардия, приглушенность тонов сердца, систолический шум, гипотония, одышка. В тяжелых случаях – гепатоспленомегалия.

Клиническая картина «Ранняя» анемия недоношенных развивается на 1 2 месяце жизни при неблагоприятном преморбидном фоне. Обусловлена низким содержанием железа, магния, меди в депо; усиленным гемолизом эритроцитов, содержащих фетальный гемоглобин; морфофункциональной незрелостью костного мозга. «Поздняя» анемия недоношенных на 3 4 месяце жизни в результате истощения неонатальных запасов железа в депо. Хлороз – своеобразная форма анемии у девочек в препубертатном и пубертатном периодах, обусловленная эндокринными факторами. Отмечается бледность с зеленоватым оттенком, слабость, утомляемость, головокружения, обмороки, сердцебиение, олиго и аменоррея. Выздоровление самопроизвольное.

Лабораторная диагностика В общем анализе крови снижение уровня гемоглобина, цветового показателя, анизоцитоз, пойкилоцитоз, микроцитоз, ретикулоцитоз. При биохимическом исследовании снижение уровня сывороточного железа (в норме Fe сыв – 14, 3 мкмоль/л), повышение железосвязывающей способности сыворотки, дис или гипопротеинемия.

Лечение ЖДА Терапия железодефицитных состояний должна быть комплексной и предусматривать устранение причины, вызвавшей заболевание, лекарственное восполнение дефицита железа и восстановление его запасов, рациональное питание с достаточным содержанием белков, витаминов, железа и других микроэлементов.

Лечение ЖДА В зависимости от содержания Fe продукты делят: Ø богатые Fe (в 100 г продуктов более 5 мг железа): печень, толокно, желток; Ø умеренно богатые Fe(в 100 г продуктов от 1 до 4 5 мг железа) куриное мясо, говядина, крупы овсяная, пшеничная, гречневая, яблоки; Ø бедные Fe (в 100 г продуктов менее 1 мг железа) морковь, клубника, виноград, молоко.

Особенности медикаментозной терапии ЖДА Для перорального приема препараты железа в виде двухвалентных солей, (гемофер, ферроград, железа глюконат, ферронат). В состав некоторых препаратов входит аскорбиновая и фолиевая кислота (сорбифер, дурулес, ферроград С, ферроплекс, ферроград фолик). Детям первых 3 лет жизни лучше применять препараты железа в жидкой форме (гемофер, мальтофер, актиферрин). В подростковом возрасте предпочтельнее препараты с пролонгированным действием (тардиферон, ферроградумент).

Особенности медикаментозной терапии ЖДА Для лучшего всасывания микроэлемента препараты железа необходимо применять за 1 2 ч до еды, запивая соком цитрусовых или клюквенным морсом. Не следует их запивать молоком или кофе, так как это снижает усвоение железа из желудочно кишечного тракта. Курс лечения должен быть длительным после нормализации Hb прием препаратов железа необходимо продолжать еще 2 3 месяца. Для парентерального введения используются препараты ферумлек, феррлецит. Они вводятся глубоко в мышцу, с интервалом в 1 2 дня.

Профилактика В антенатальном периоде: борьба с невынашиванием беременности, лечение гестозов, санация очагов инфекции, соблюдение режима дня, рациональное питание. В постнатальном периоде: естественное вскармливание, своевременная коррекция питания и введение прикорма, предупреждение заболеваний, диспансерное наблюдение за детьми раннего возраста с регулярным лабораторным исследованием крови, профилактическое введение препаратов железа детям из группы риска.

Профилактика дефицита железа Группы риска: • Недоношенные младенцы (в теч. 2 лет) • Дети многоплодной беременности • Дети первого года жизни • Девочки подростки • Дети спортсмены • Вегетарианцы

ОСТРЫЙ ЛЕЙКОЗ Лейкоз злокачественное заболевание кроветворной ткани с первичной локализацией процесса в костном мозге и последующим метастазированием в другие органы. У детей лейкоз встречается чаще, чем другие злокачествен ные опухоли. Пик заболеваемости приходится на возраст 3, 5 4 года.

Этиология, патогенез В развитии заболевания имеет значение наследственная предрасположенность и влияние мутагенных факторов внешней среды: радиация, химические вещества (бензол, продукты перегонки нефти) и онковирусы. Согласно клоновой теории, клетка мутант утрачивает способность к созреванию и начинает безудержно размножаться. Все лейкозные клетки являются потомками одной мутировавшей клетки родоначальной. Лейкозная опухоль вытесняет нормальные ростки кроветворения, распространяется по организму с развитием лейкемических инфильтратов (метастазов). Характерным признаком острого лейкоза является увеличение количества бластных клеток в костном мозге. В зависимости от того, каким типом бластов (миелобласты, лимфобласты, монобласты, эритробласты и недифференцируемые бласты) представлены лейкемические инфильтраты, острые лейкозы делят на соответствующие формы. Наиболее распространенными формами заболевания у детей являются миелобластный и лимфобластный лейкозы.

Клиническая картина Острый лейкоз часто протекает под маской других заболеваний: ангин, анемий, гриппа, сепсиса. Клинические симптомы в разгар заболевания: лихорадка, частые инфекции, анемический, геморрагический, костно суставной, пролиферативный синдром. Кровоизлияния в кожу и кровотечения из слизистых оболочек носа, десен и внутренних органов. Пролиферативный синдром: увеличение печени, селезенки, периферических лимфоузлов шейных, подчелюстных, подмышечных, паховых. Поражение костной системы: летучие боли в суставах, болезненность в костях черепа, позвоночника, по ходу трубчатых костей. При поражении нервной системы развивается нейролейкемия (головная боль, тошнота, рвота, сонливость, снижение зрения и слуха, нарушение психики и речи, судороги, парезы и параличи, коматозное состояние. ) Присоединение вторичной инфекции (сепсис, вирусные инфекции, язвенно некротический энтероколит).

Лабораторная диагностика Диагностические критерии острого лейкоза: 1) появление в периферической крови незрелых клеток бластов; 2) анемия; 3) тромбоцитопения. К менее постоянным признакам относятся увеличение или снижение количества лейкоцитов, ускоренная СОЭ. Характерным гематологическим признаком острого лейкоза является обрыв кроветворения на раннем этапе, вследствие чего между юными клетками и зрелыми лейкоцитами отсутствуют переходные формы ("лейкемическое зияние"). Диагноз острого лейкоза подтверждается, если в пунктате костного мозга обнаружено более 30% бластных клеток.

Лечение Ведущими методами в лечении являются химио и лучевая терапия, пересадка костного мозга. Для химиотерапии используют комбинацию препаратов шести фарм. групп: 1) антиметаболиты метотрексат, меркаптопурин, циторабин; 2) противоопухолевые антибиотики блеомицин, дактиномцин, рубомцин; 3) алкалоиды растений винбластин, винкристин; 4) ферментные препараты L аспарагиназа; 5) алкилирующие соединения циклофосфан, миелосан; 6) гормоны преднизолон, дексаметазон и др. Химиотерапию проводят на фоне инфузионной терапии (т. к. лечение цитостатиками сопровождается усилением интоксикации из за массивного распада опухоли). При выраженной анемии, геморрагическом синдроме показано переливание эритроцитарной и тромбоцитарной массы.

Уход Особое значение в уходе за больными, получающими цитостатики, имеет создание асептических условий и лечебно охранительного режима. Больного помещают в бокс с бактерицидными лампами для стерилизации воздуха. Влажная уборка помещения с последующим проветриванием 3 раза в сутки. Не реже 1 раза в неделю генеральная уборка с применением дез. растворов. Перед входом в бокс медперсонал обязан протереть обувь о коврик, смоченный дезинфектантом, надеть бахилы, маску, дополнительный халат. Для предупреждения развития инфекционных осложнений важно удалить микробную флору с поверхности кожи. Ребенку ежедневно проводят гигиеническую ванну или обмывают кожу. Уход за кожей должен быть щадящим: запрещаются горячие ванны и душ, вместо жестких мочалок используют мягкие губки или фланелевые варежки. Смена нательного и постельного белья проводится ежедневно.

Уход Важное значение имеет уход за полостью рта. При набухших, разрыхленных и кровоточащих деснах не рекомендуется чистить зубы щеткой. Эту процедуру заменяют полосканием или орошением слизистой полости рта 1 2% раствором натрия бикарбоната, фурацилина, отварами шалфея, ромашки. Можно смазывать слизистую оболочку 1 2% водным раствором анилиновых красителей, натрия бората в глицерине. Полость рта обрабатывают утром натощак и после каждого приема пищи. Диета должна быть высококалорийной с увеличением количества белка по сравнению с возрастной нормой, богатой минеральными веществами и витаминами (стол № 10 а). При назначении глюкокортикоидов рацион обогащается солями калия и кальция.
Анемии у детей .pptx